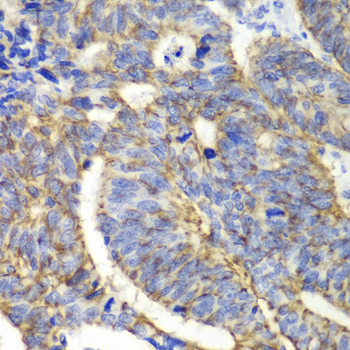
A2196: image 4

For quotations, please use our online quotation form, and you may also contact us by
sales@neoscientific.com
+1-888.733.6849
+1-617.299.7367 (Int’l)
+1-888.733.6849
+1-617.299.7367 (Int’l)
| Reactivity | Human Mouse Rat |
| Tested applications | WB IHC |
| Recommended Dilution | WB 1:500 - 1:2000 IHC 1:50 - 1:200 |
| Calculated MW | 23kDa |
| Observed MW | Refer to Figures |
| Immunogen | Recombinant protein of human CLDN1 |
| Storage Buffer | Store at -20℃. Avoid freeze / thaw cycles. Buffer: PBS with 0.02% sodium azide, 50% glycerol, pH7.3. |
| Synonym | CLD1; ILVASC; SEMP1; |

Western blot analysis of extracts of various cell lines, using CLDN1 antibody.

Immunohistochemistry of paraffin-embedded rat kidney using CLDN1 antibody at dilution of 1:100 (400x lens).

Immunohistochemistry of paraffin-embedded human lung cancer using CLDN1 antibody at dilution of 1:100 (400x lens).
Immunohistochemistry of paraffin-embedded human colon carcinoma using CLDN1 antibody at dilution of 1:100 (400x lens).

Immunohistochemistry of paraffin-embedded human esophageal using CLDN1 antibody at dilution of 1:100 (400x lens).
Tight junctions, or zonula occludens, form a continuous barrier to fluids across the epithelium and endothelium. They function in regulation of paracellular permeability and in the maintenance of cell polarity, blocking the movement of transmembrane proteins between the apical and the basolateral cell surfaces. Tight junctions are composed of claudin and occludin proteins, which join the junctions to the cytoskeleton (1,2). The claudin family is composed of 23 integral membrane proteins, and their expression, which varies among tissue types, may determine both the strength and properties of the epithelial barrier. Alteration in claudin protein expression pattern is associated with several types of cancer (2,3). Claudin-1 is expressed primarily in keratinocytes (4) and normal mammary epithelial cells, but is absent or reduced in breast carcinomas and breast cancer cell lines (5,6).
N/A